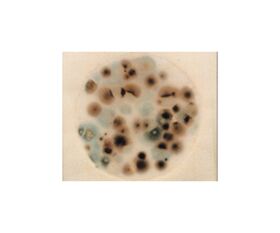

説明
【特徴】
●検査工程を簡単にし、標準化することが可能。
●均一な乾式フィルム状のできあがり培地です。
●培地調整は不要です。
●指示薬によりコロニーが染色され、数えやすいです。
●使用後の廃棄が容易です。
●保管および培養時のスペースを取りません。
●スタンプ法としても使用できます。
●ペトリフィルム™ 培地は世界60ヶ国以上で使用され、200種以上の承認|推薦を取得。(AOAC Intl.OMA、AFNOR他多数)
●※AOAC Intl.OMA(Official Methods of Analysis)の承認は、最も高い信頼性を要求する試験法に適応される試験方法で、FDA(米国食品医薬品局)においても使用されている検査方法の1つです。
【仕様】
●付属品:スプレッダー1個
●カビ|酵母測定用
●入数:1箱(50枚/袋×2袋入)
●★輸送条件:常温
追加情報
メーカー名:
ネオジェンジャパン
メーカー品番:
6407YM
予定納期:
注文から1~3日で発送